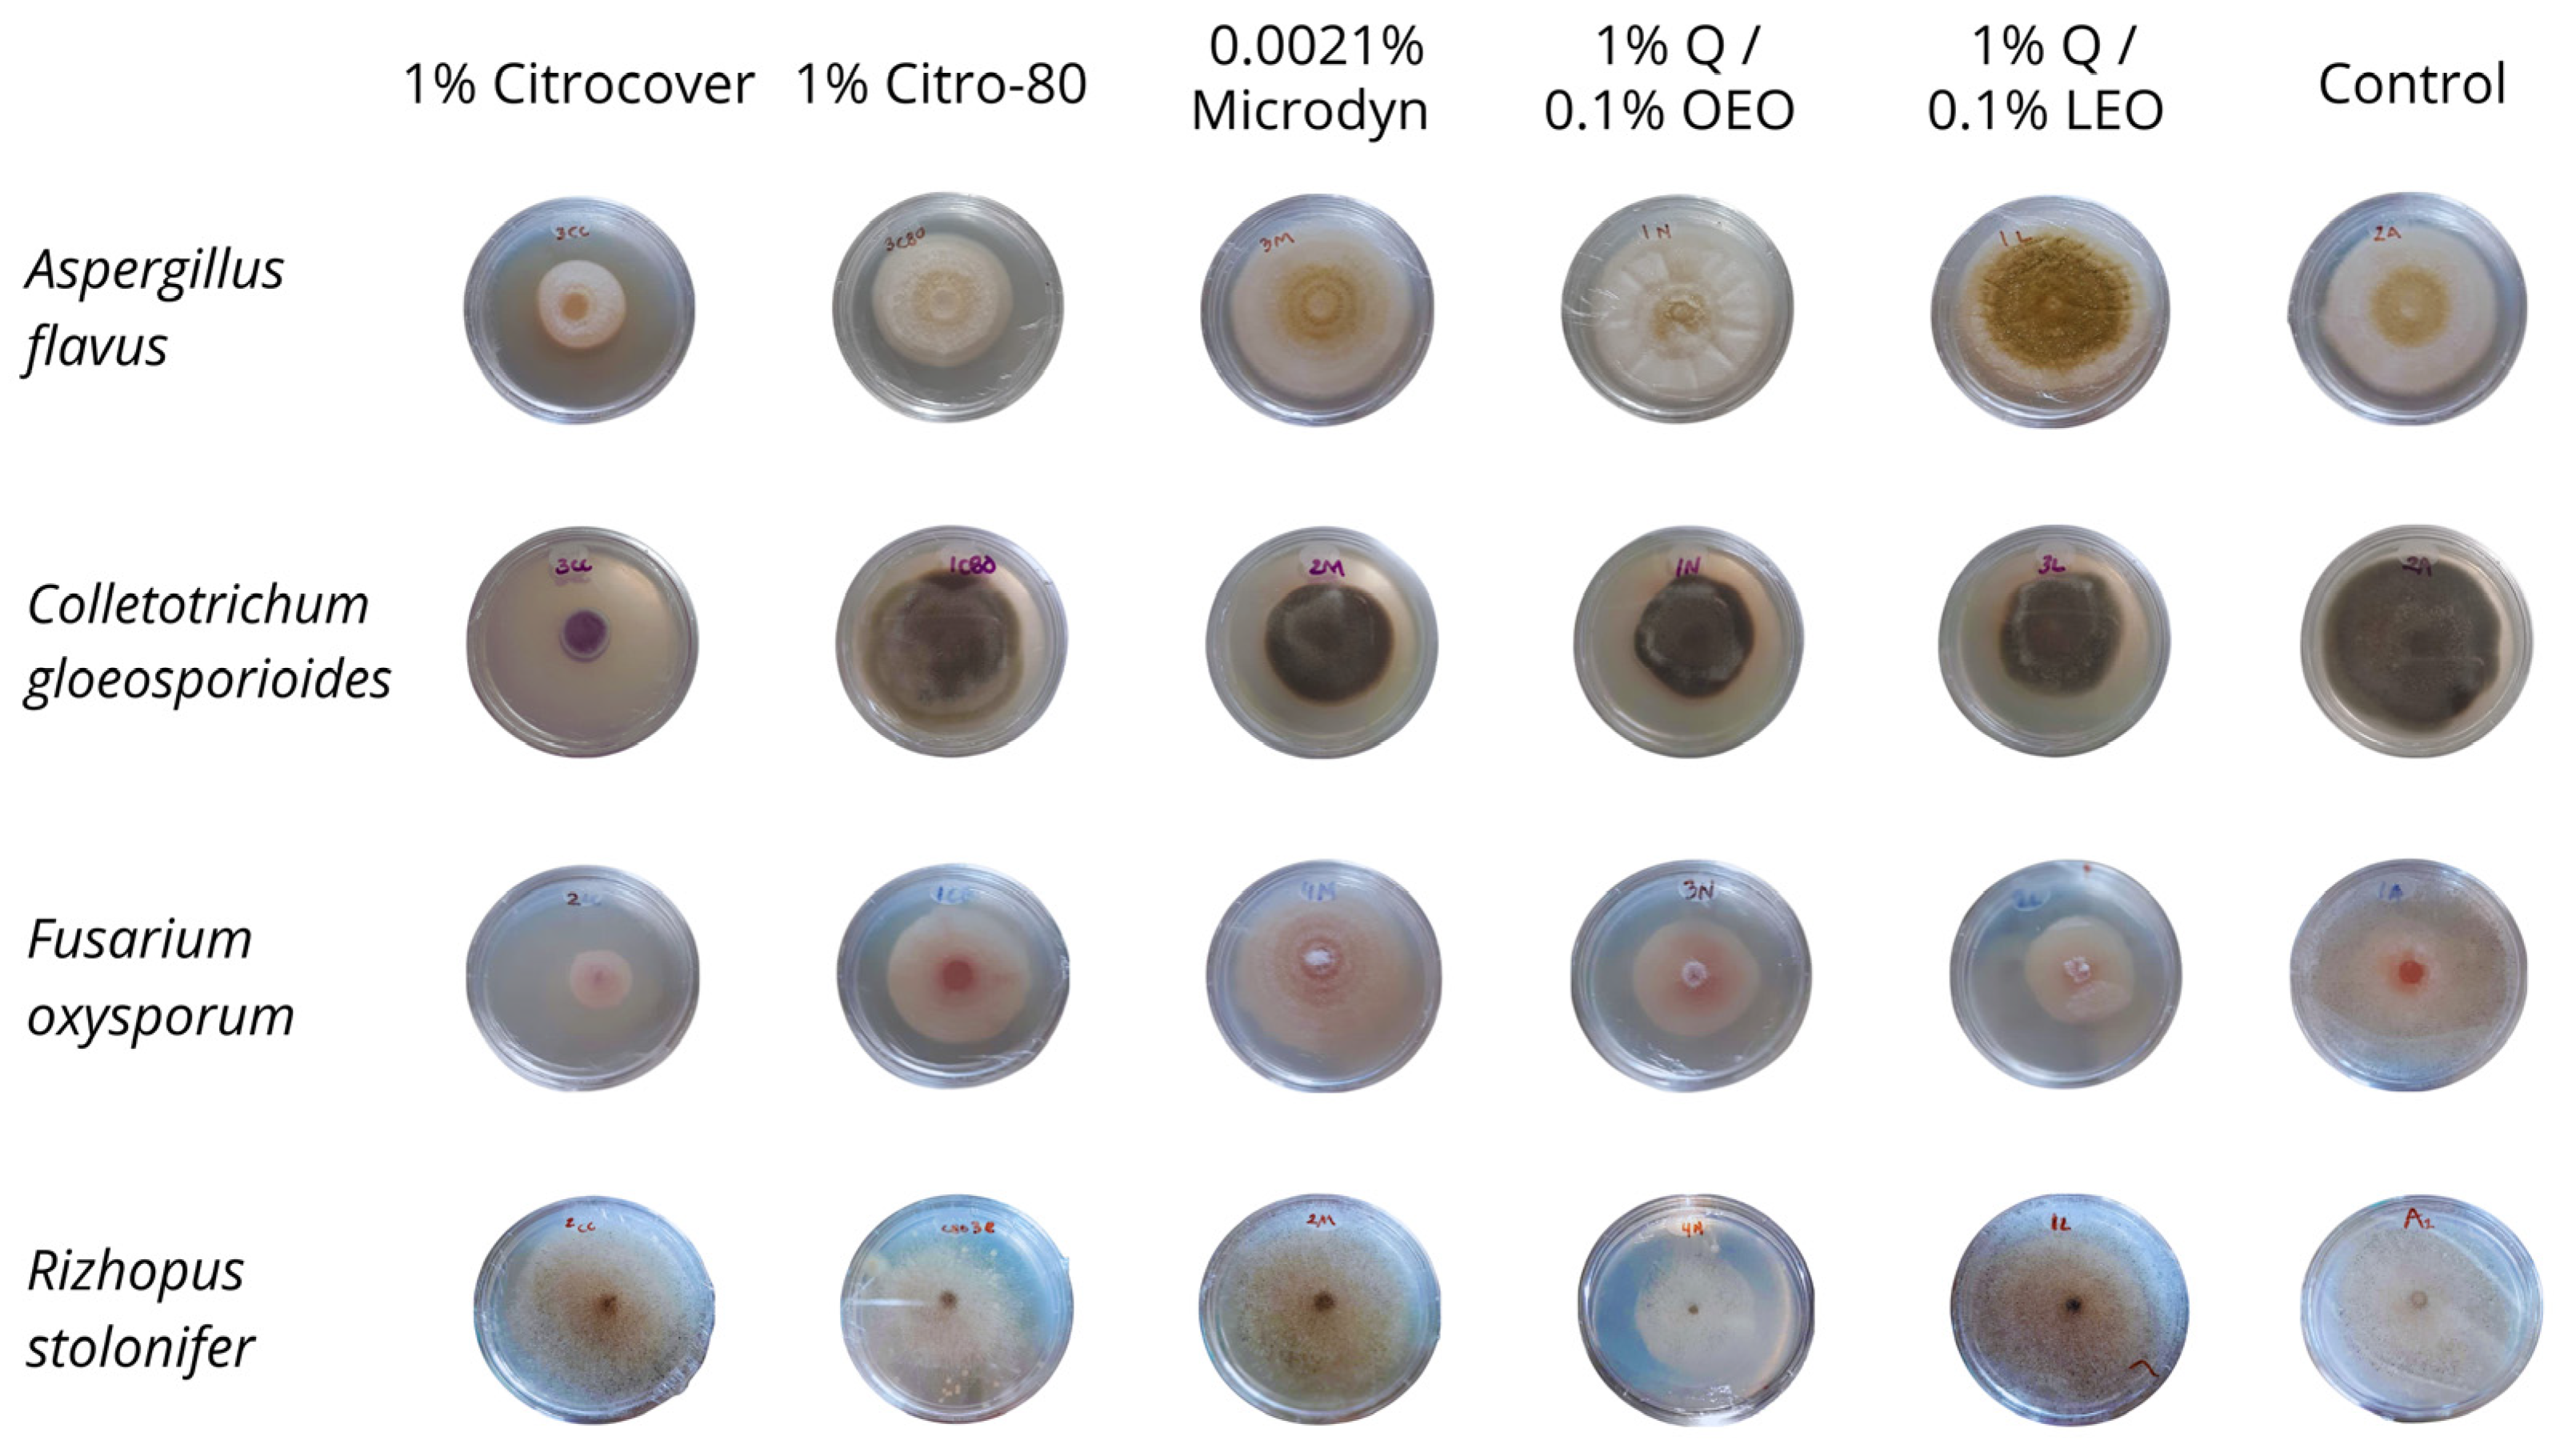
Jof 10 00309 g005

The Response of Naturally Based Coatings and Citrus Fungicides to the Development of Four Postharvest Fungi
Abstract
:1. Introduction
2. Materials and Methods
2.1. Selection of Fungal Strains
2.2. Commercial Products
2.3. Chitosan Essential Oil Coatings
2.3.1. Chitosan Obtention
2.3.2. Essential Oil Obtention
2.3.3. Coatings
2.4. Treatments
2.5. Tomato Fruit
2.6. Antifungal Analysis
2.7. Mycotoxin Production In Vitro and on Inoculated Tomatoes
2.8. Ripening of Treated Tomatoes
2.9. Statistical Analysis
3. Results
3.1. In Vitro Growth and Disease Development on Inoculated Tomatoes
3.2. Spore Germination
3.3. Mycotoxin Production In Vitro and on Inoculated and Dehydrated Tomatoes
3.4. Storage Behavior of the Treated Tomatoes
4. Discussion
5. Conclusions
Author Contributions
Funding
Institutional Review Board Statement
Informed Consent Statement
Data Availability Statement
Acknowledgments
Conflicts of Interest
References
- FAO. Organización de las Naciones Unidas para la Alimentación y la Agricultura. Antecedentes|Plataforma Técnica Sobre la Medición y la Reducción de las Pérdidas y el Desperdicio de Alimentos. 2021. Available online: https://www.fao.org/platform-food-loss-waste/background/es (accessed on 13 March 2024).
- Barkai-Golan, R. Aspergillus Mycotoxins. In Mycotoxins in Fruits and Vegetables; Barkai-Golan, R., Paster, N., Eds.; Academic Press: Cambridge, MA, USA; Elsevier: Amsterdam, The Netherlands, 2008; pp. 115–151. [Google Scholar]
- Ji, F.; He, D.; Olaniran, A.O.; Mokoena, M.O.; Shu, J.; Shi, J. Occurrence, toxicity, production and detection of Fusarium mycotoxin: A review. Food Prod. Process. Nutr. 2019, 1, 6. [Google Scholar] [CrossRef]
- Ruiz, M.J.; Vicente, A.V.; Montañéz, S.J.; César Rodríguez, H.R.; Aguilar, G.C.N. Un tesoro perecedero en México: El tomate, tecnologías para prolongar su vida de anaquel. Investig. Cienc. 2012, 20, 57–63. [Google Scholar]
- Rodríguez-Guzmán, C.A.; Montaño-Leyva, B.; Velázquez-Estrada, R.M.; Sánchez-Burgos, J.A.; García-Magaña, M.d.L.; González-Estrada, R.R.; Gutiérrez-Martínez, P. Estado actual de métodos alternativos, de control de hongos y su efecto en la calidad postcosecha de frutos de jitomate (Solanum lycopersicum). TIP Rev. Esp. Cienc. Quím. Biol. 2021, 24, 1–15. [Google Scholar] [CrossRef]
- Shamurailatpam, D.; Kumar, A. A review on recent methods to control early blight of tomato (Solanum lycopersicum L.). Plant Cell Biotechnol. Mol. Biol. 2020, 21, 136–148. [Google Scholar]
- Carvalho, F.P. Agriculture, pesticides, food security and food safety. Environ. Sci. Policy 2006, 9, 685–692. [Google Scholar] [CrossRef]
- Shridhar, B.P.; Sharma, M.; Gupta, S.K.; Sharma, S.K. New generation fungicides for the management of buckeye rot of tomato. Indian Phytopathol. 2018, 71, 621–625. [Google Scholar] [CrossRef]
- Xu, G.; Liu, D.; Chen, J.; Ye, X.; Shi, J. Composition of major flavanone glycosides and antioxidant capacity of three citrus varieties. J. Food Biochem. 2009, 33, 453–469. [Google Scholar] [CrossRef]
- Bashir, L.U.; Abdulkadir, A.; Shah, M.M.; Hamisu, A.; Sharif, U.; Kamalu, A.A. Phytochemical screening and antifungal potentials of Citrus limon peels against Fusarium oxysporum and Rhizopus stolonifer causing rots in water melon (Citrullus lanatus L.). J. Exp. Sci. 2020, 11, 17–21. [Google Scholar] [CrossRef]
- Bautista-Baños, S.; Ventura-Aguilar, R.I.; Correa-Pacheco, Z.; Corona-Rangel, M.L. Chitosan: A versatile antimicrobial polysaccharide for fruit and vegetables in postharvest—A review. Rev. Chapingo Ser. Hortic. 2017, 23, 103–121. [Google Scholar] [CrossRef]
- Narváez, B.F.J.; Barzola, M.S.E.; Fon-Fay, V.F.M.; Martínez, C.M.J.; Neira, M.J.A.; Sánchez, L.S.N. Potencial antifúngico de Citrus sinensis y Citrus nobilis sobre el crecimiento de Rhizopus stolonifer y Colletotrichum gloeosporioides en papaya. Cienc. Tecnol. 2017, 10, 41–46. [Google Scholar] [CrossRef]
- Negera, M.; Washe, A.P. Use of natural dietary spices for reclamation of food quality impairment by aflatoxin. J. Food Qual. 2019, 2019, 4371206. [Google Scholar] [CrossRef]
- Liu, Y.; Benohoud, M.; Galani, Y.J.H.; Gong, Y.Y.; Orfila, C. Green extraction of polyphenols from citrus peel by-products and their antifungal activity against Aspergillus flavus. Food Chem. X 2021, 12, 100144. [Google Scholar] [CrossRef] [PubMed]
- Velásquez, M.; Álvarez, R.; Tamayo, P.; Carvalho, C. Evaluación in vitro de la actividad fungistática del aceite esencial de mandarina sobre el crecimiento de Penicillium sp. Cienc. Tecnol. Agropecu. 2015, 15, 7–14. [Google Scholar] [CrossRef]
- Sheikh, M.; Mehnaz, S.; Sadiq, M.B. Prevalence of fungi in fresh tomatoes and their control by chitosan and sweet orange (Citrus sinensis) peel essential oil coating. J. Sci. Food Agric. 2021, 101, 6248–6257. [Google Scholar] [CrossRef] [PubMed]
- Cheng, Y.J.; Wu, Y.J.; Lee, F.W.; Ou, L.Y.; Chen, C.N.; Chu, Y.Y.; Kuan, Y.-C. Impact of storage condition on chemical composition and antifungal activity of pomelo extract against Colletotrichum gloeosporioides and anthracnose in post-harvest mango. Plants 2022, 11, 2064. [Google Scholar] [CrossRef] [PubMed]
- Rangel-Vargas, E.; Gutiérrez-Alcántara, E.J.; Gómez-Aldapa, C.A.; Falfán-Cortés, R.N.; Segovia-Cruz, J.A.; Salas-Rangel, L.P.; Castro-Rosas, J. Antibacterial activity of roselle calyx extracts, sodium hypochlorite, colloidal silver and acetic acid against multidrug-resistant salmonella serotypes isolated from coriander. J. Food Saf. 2017, 37, e12320. [Google Scholar] [CrossRef]
- Salgado-Escobar, I.; Hernández-Rodríguez, G.; Suárez-López, Y.d.C.; Mancera-Ugarte, M.J.; Guerra-Ramíez, D. Eficacia de métodos de desinfección y los efectos sobre las propiedades nutracéuticas en cilantro y fresa. Rev. Mex. Cienc. Agríc. 2020, 11, 327–337. [Google Scholar] [CrossRef]
- Venat, O.; Iacomi, B.; Peticila, A.G. In Vitro studies of antifungal activity of colloidal silver against important plants pathogens. Not. Bot. Horti Agrobot. Cluj-Napoca 2018, 46, 533–537. [Google Scholar] [CrossRef]
- Cortes-Higareda, M.; Ramos-García, M.L.; Correa-Pacheco, Z.; Del Rio, J.C.; Bautista-Baños, S. Nanostructured chitosan/propolis formulations: Characterization and effect on the growth of Aspergillus flavus and production of aflatoxins. Heliyon 2019, 5, e01776. [Google Scholar] [CrossRef]
- Ventura-Aguilar, R.I.; Gónzalez-Andrade, C.; Hernández-López, M.; Correa-Pacheco, Z.N.; Teksür, P.K.; Ramos-García, M.d.L.; Bautista-Baños, S. Effect of biodegradable coatings on the growth of Aspergillus flavus in vitro, on maize grains, and on the quality of tortillas during storage. Molecules 2022, 27, 4545. [Google Scholar] [CrossRef]
- Asfaw, M.D. Basic essential oil extraction techniques and procedures from aromatic plants. J. Chromatogr. Sep. Tech. 2022, 13, 1–5. [Google Scholar]
- Aparicio-García, P.F.; Ventura-Aguilar, R.I.; Río-García, J.C.; Hernández-López, M.; Guillén-Sánchez, D.; Salazar-Pina, D.A.; Ramos-García, M.d.L.; Bautista-Banos, S. Edible chitosan/propolis coatings and their effect on ripening, development of Aspergillus flavus, and sensory quality in fig fruit, during controlled storage. Plants 2021, 10, 112. [Google Scholar] [CrossRef] [PubMed]
- Rodríguez, D.A.; Montilla, J.O. Disminución de la marchitez causada por Fusarium en tomate con extracto de Citrus paradisi. Integr. Plagas 2002, 46–50. [Google Scholar]
- Segura-Palacios, M.A.; Correa-Pacheco, Z.N.; Corona-Rangel, M.L.; Martinez-Ramirez, O.C.; Salazar-Pina, D.A.; Ramos-García, M.d.L.; Bautista-Banos, S. Use of natural products on the control of Aspergillus flavus and production of aflatoxins in vitro and on tomato fruit. Plants 2021, 10, 2553. [Google Scholar] [CrossRef] [PubMed]
- Sanver, D.; Murray, B.S.; Sadeghpour, A.; Rappolt, M.; Nelson, A.L. Experimental modeling of flavonoid-biomembrane interactions. Langmuir 2016, 32, 13234–13243. [Google Scholar] [CrossRef] [PubMed]
- Makarewicz, M.; Drożdż, I.; Tarko, T.; Duda-Chodak, A. The interactions between polyphenols and microorganisms, especially gut microbiota. Antioxidants 2021, 10, 188. [Google Scholar] [CrossRef] [PubMed]
- Tian, F.; Woo, S.Y.; Lee, S.Y.; Park, S.B.; Zheng, Y.; Chun, H.S. Antifungal activity of essential oil and plant-derived natural compounds against Aspergillus flavus. Antibiotics 2022, 11, 1727. [Google Scholar] [CrossRef] [PubMed]
- Villegas-Rascón, R.E.; Plascencia-Jatomea, M.; Rosas-Burgos, E.C.; López-Franco, Y.L.; Tánori-Córdova, J.C.; López-Meneses, A.K.; Cortez-Rocha, M.O. Chitosan/essential oils biocomposites for suppressing the growth of Aspergillus parasiticus. Int. Food Res. J. 2020, 27, 316–326. [Google Scholar]
- Ruíz-Alvarado, C.; Reyes-Pérez, J.J.; Hernández-Montiel, L.G.; Murillo, B.; Rueda, E. Control of phytopathogenic microorganisms of post-harvest in tomato (Lycopersicon esculentum Mill.) with the use of citrus extract. J. Plant Sci. Phytopathol. 2018, 2, 037–043. [Google Scholar]
- Coutiño, R.E.M. Plata Coloidal: Xenobiótico, Antígeno y Disruptor Hormonal. Rev. Educ. Bioquím. 2015, 34, 1–14. [Google Scholar]
- Silver, S. Bacterial silver resistance: Molecular biology and uses and misuses of silver compounds. FEMS Microbiol. Rev. 2003, 27, 341–353. [Google Scholar] [CrossRef]
- Prusky, D.; Romannazi, G. Induced resistance in fruit and vegetables: A host physiological response limiting postharvest disease development. Annu. Rev. Phytopathol. 2023, 61, 279–300. [Google Scholar] [CrossRef] [PubMed]
- López-Vidal, O.; Escalona-Buendía, H.; Pelayo-Zaldívar, C.; Cruz-Salazar, J.; Villa-Hernández, J.M.; Rivera-Cabrera, F.; Villegas-Torres, O.; Alia-Tejacal, I.; Pérez-Flores, L.J.; De León-Sánchez, F.D. Carotenoid content, antioxidant capacity and volatile compounds of the aroma during tomato ripening. Phyton 2014, 83, 185–192. [Google Scholar] [CrossRef]
- Bautista-Baños, S.; González-Soto, R.; Ramos-García, M.L. Physical properties of chitosan films with lemon essential oil added and their impact on the shelf life of tomatoes (Lycopersicon esculentum L.). Rev. Mex. Ing. Quim. 2018, 17, 1–11. [Google Scholar] [CrossRef]

| Treatments | Fungi | |||
|---|---|---|---|---|
| Aspergillus flavus | Fusarium oxysporum | |||
| In Vitro (ppb) | Dry Tomatoes (ppb) | In Vitro (ppm) | Dry Tomatoes (ppm) | |
| 1% Citrocover | 0.1 a,* | 1.3 a | 0.16 b | 0.19 a |
| 1% Citro-80 | 0.1 a | 1.4 a | 0.15 b | 0.66 c |
| 0.002% Microdyn | 0.3 b | 1.7 b | 0.10 a | 0.56 b |
| 1% Q/0.1% OEO | 0.4 c | 1.4 a | 0.18 b | 0.43 c |
| 1% Q/0.1% LEO | 0.2 a | 1.6 b | 0.18 b | 0.72 d |
| Control | 0.5 d | 1.6 b | 0.21 b | 0.67 c |
Disclaimer/Publisher’s Note: The statements, opinions and data contained in all publications are solely those of the individual author(s) and contributor(s) and not of MDPI and/or the editor(s). MDPI and/or the editor(s) disclaim responsibility for any injury to people or property resulting from any ideas, methods, instructions or products referred to in the content. |
© 2024 by the authors. Licensee MDPI, Basel, Switzerland. This article is an open access article distributed under the terms and conditions of the Creative Commons Attribution (CC BY) license (https://creativecommons.org/licenses/by/4.0/).
Share and Cite
Serrano-Molina, L.; Hernández-López, M.; Salazar-Piña, D.A.; Bautista-Baños, S.; Ramos-García, M.d.L. The Response of Naturally Based Coatings and Citrus Fungicides to the Development of Four Postharvest Fungi. J. Fungi 2024, 10, 309. https://doi.org/10.3390/jof10050309
Serrano-Molina L, Hernández-López M, Salazar-Piña DA, Bautista-Baños S, Ramos-García MdL. The Response of Naturally Based Coatings and Citrus Fungicides to the Development of Four Postharvest Fungi. Journal of Fungi. 2024; 10(5):309. https://doi.org/10.3390/jof10050309
Chicago/Turabian StyleSerrano-Molina, Lizette, Mónica Hernández-López, Dolores Azucena Salazar-Piña, Silvia Bautista-Baños, and Margarita de Lorena Ramos-García. 2024. "The Response of Naturally Based Coatings and Citrus Fungicides to the Development of Four Postharvest Fungi" Journal of Fungi 10, no. 5: 309. https://doi.org/10.3390/jof10050309





